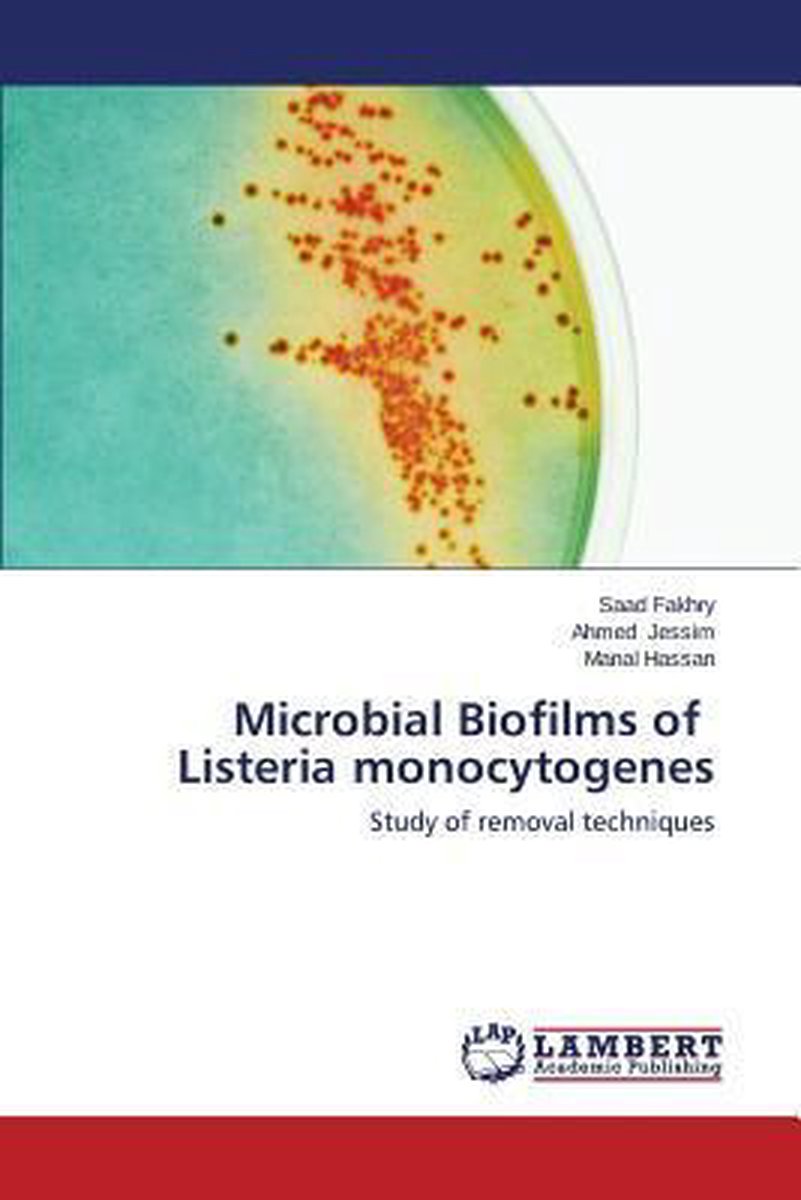

We hebben 1 boek gevonden van de auteur Fakhry Saad
Hieronder vindt u een lijst met alle gevonden boeken van de auteur Fakhry Saad.
Het enige gevonden boek is Microbial Biofilms Of Listeria Monocytogenes.
Het enige gevonden boek is Microbial Biofilms Of Listeria Monocytogenes.
Sorteer op: